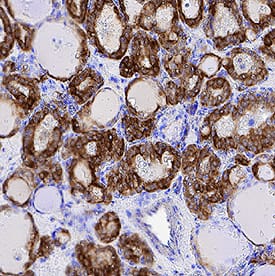
Cytokeratin 19 antibody in Human Papillary Thyroid Cancer Tissue by Immunohistochemistry (IHC-P).

Human Cytokeratin 19 Antibody
R&D Systems, part of Bio-Techne | Catalog # MAB35061


Key Product Details
Validated by
Species Reactivity
Applications
Label
Antibody Source
Product Specifications
Immunogen
Gln311-Lys370
Accession # P08727
Specificity
Clonality
Host
Isotype
Scientific Data Images for Human Cytokeratin 19 Antibody
Cytokeratin 19 in Human Breast Cancer Tissue Using Dual RNAscope®ISH and IHC.
Cytokeratin 19 mRNA (red) and protein (green) was detected in formalin-fixed paraffin-embedded tissue sections of human breast cancer tissue probed with ACD RNAScope®Probe (Catalog # 310221) followed by immunohistochemistry using R&D Systems Mouse Anti-Human Cytokeratin 19 Monoclonal Antibody (Catalog # MAB35061) at 15ug/mL for 1 hour at room temperature followed by incubation with the Anti-Mouse IgG VisUCyte HRP Polymer Antibody (R&D Systems, Catalog # VC001). Tissue was stained using ACD RNAscope®2.5 HD Duplex Detection Reagents (Catalog # 322500).Detection of Human Cytokeratin 19 by Western Blot.
Western blot shows lysates of HT-29 human colon adenocarcinoma cell line, ZR-75 human breast cancer cell line, DU145 human prostate carcinoma cell line, MCF-7 human breast cancer cell line, and A431 human epithelial carcinoma cell line. PVDF membrane was probed with 0.25 µg/mL of Mouse Anti-Human Cytokeratin 19 Monoclonal Antibody (Catalog # MAB35061) followed by HRP-conjugated Anti-Mouse IgG Secondary Antibody (Catalog # HAF018). A specific band was detected for Cytokeratin 19 at approximately 40 kDa (as indicated). This experiment was conducted under reducing conditions and using Immunoblot Buffer Group 1.Cytokeratin 19 in MCF‑7 Human Cell Line.
Cytokeratin 19 was detected in immersion fixed MCF-7 human breast cancer cell line using Mouse Anti-Human Cytokeratin 19 Monoclonal Antibody (Catalog # MAB35061) at 8 µg/mL for 3 hours at room temperature. Cells were stained using the NorthernLights™ 557-conjugated Anti-Mouse IgG Secondary Antibody (red; Catalog # NL007) and counterstained with DAPI (blue). Specific staining was localized to cytoplasm. View our protocol for Fluorescent ICC Staining of Cells on Coverslips.Applications for Human Cytokeratin 19 Antibody
Dual RNAscope ISH-IHC Compatible
Immunocytochemistry
Sample: Immersion fixed MCF-7 human breast cancer cell line
Immunohistochemistry
Sample: Immersion fixed paraffin-embedded sections of human breast cancer tissue, human gastric cancer tissue, human papillary thyroid cancer tissue and human lymphoma tissue
Simple Western
Sample: MCF‑7 human breast cancer cell line and HT‑29 human colon adenocarcinoma cell line
Western Blot
Sample: HT‑29 human colon adenocarcinoma cell line, ZR‑75 human breast cancer cell line, DU145 human prostate carcinoma cell line, MCF‑7 human breast cancer cell line, and A431 human epithelial carcinoma cell line
Reviewed Applications
Read 1 review rated 5 using MAB35061 in the following applications:
Formulation, Preparation, and Storage
Purification
Reconstitution
Formulation
Shipping
Stability & Storage
- 12 months from date of receipt, -20 to -70 °C as supplied.
- 1 month, 2 to 8 °C under sterile conditions after reconstitution.
- 6 months, -20 to -70 °C under sterile conditions after reconstitution.
Background: Cytokeratin 19
Cytokeratin 19 (Keratin, type I cytoskeletal 19; also KRT-19, CK19 and Keratin-19) is a 40-45 kDa, acidic Class I keratin member of the intermediate filament family of proteins. Individual keratins are always expressed in tandem with a second keratin, and these are found in all epithelial cells. The class I KRT-19 heterodimerizes/polymerizes with 50-52 kDa class II KRT-8 (plus KRT-5 and -7) to form 8-10 nm filaments in epidermal stem cells, secretory gland (sweat; mammary; bile duct) simple epithelium, and neuroendocrine epidermal Merkel cells. It may represent a viable marker for skin stem cells. In skin, Cytokeratin 19 forms filaments in the fetal epithelium, and then progressively decreases with age, being virtually absent by age 17. Human Cytokeratin 19 is 400 amino acids (aa) in length. It contains an N-terminal "head" region (aa 1-79) and a subsequent "rod" region (aa 80-387), but is absent a typical C-terminal tail region. Cytokeratin 19 possesses at least 5 utilized phosphorylation sites plus one acetylated Lys residue. Based on other keratins, and the presence of an Asp at position 238, there may be caspase cleavage-generated isoforms. Full length human Cytokeratin 19 (aa 2-400) shares 82% aa sequence identity with mouse Cytokeratin 19.
Alternate Names
Gene Symbol
UniProt
Additional Cytokeratin 19 Products
Product Documents for Human Cytokeratin 19 Antibody
Product Specific Notices for Human Cytokeratin 19 Antibody
For research use only